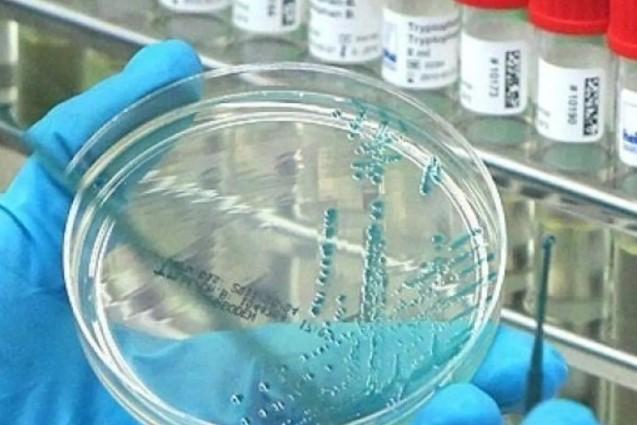
Ilmuwan Rusia Kembangkan Vaksin Baru untuk Flu Burung H5N1 yang Lebih Efektif dan Aman

Pantau - Selain berperan penting dalam pembentukan dan pemeliharaan tulang serta mendukung fungsi kekebalan dan otot, vitamin D memiliki sifat antiradang dan neuroprotektif menurut informasi Mayo Clinic.
Dikutip Well and Good, sebagaimana dilansir Antara, Selasa (21/1/2025), dokter keluarga bersertifikat di Providence Saint John's Health Center di Amerika Serikat, David Cutler, M.D. menyampaikan bahwa kekurangan sedikit asupan vitamin D tidak akan menimbulkan masalah.
Rekomendasi asupan vitamin D harian sekitar 600 IU atau sekitar 15 mikrogram. Dokter Cutler menyampaikan bahwa kekurangan sedikit asupan vitamin D biasanya tidak menimbulkan gejala gangguan.
Baca juga: 6 Manfaat Vitamin C untuk Wajah yang Perlu Diketahui
Namun, Kimberly Gomer, R.D.N, ahli diet terdaftar di California, Amerika Serikat, menyampaikan bahwa kekurangan vitamin D parah atau kronis bisa menimbulkan gejala
Berikut tanda-tanda tubuh kekurangan vitamin D.
1. Infeksi saluran kemih
Kekurangan vitamin D berpengaruh pada risiko infeksi saluran kemih menurut hasil meta-analisis dari sembilan penelitian yang diterbitkan dalam Annals of Clinical & Laboratory Science.
Gomer menyampaikan bahwa kecukupan asupan vitamin D sangat penting untuk menjaga fungsi kekebalan tubuh, termasuk merangsang produksi senyawa antimikroba yang diperlukan untuk melawan bakteri penyebab infeksi saluran kemih.
Baca juga: 7 Tanda Tubuh Kekurangan Vitamin C yang Perlu Kamu Tahu
2. Kulit pucat
Perubahan kulit menjadi lebih pucat bisa jadi menandakan tubuh kekurangan vitamin D menurut Gomer.
3. Rambut rontok
Rambut rontok termasuk penanda masalah kesehatan. Menurut ulasan di Journal of Cosmetic Dermatology, dalam beberapa kasus kerontokan rambut bisa terjadi karena rendahnya asupan vitamin D. Zat nutrisi tersebut berperan dalam merangsang pertumbuhan folikel rambut. Kadar vitamin D yang tidak memadai dalam tubuh dikaitkan dengan kerontokan rambut.
4. Kelemahan atau kejang otot
Vitamin D berperan dalam penyerapan kalsium yang juga untuk membantu mencegah kondisi yang disebut tetani hipokalsemik, istilah medis untuk kontraksi otot tak sadar yang menyebabkan kejang, kram, dan kelemahan otot.
5. Perubahan suasana hati
Gomer mengatakan bahwa vitamin D juga berperan dalam pengaturan sekresi serotonin dan melatonin, yang berpengaruh pada suasana hati.
Menurut makalah dalam Current Nutrition Reports, serotonin mengatur suasana hati, sementara melatonin berperan dalam pengaturan tidur. Keduanya berperan penting dalam pencegahan gangguan suasana hati.
Semakin sedikit serotonin dan melatonin yang diproduksi tubuh, semakin tinggi risiko mengalami gejala suasana hati buruk.
Baca juga: Ahli Gizi Sebut Vitamin A dan C Penting Dikonsumsi saat Musim Hujan
6. Sering Pilek
Vitamin D menurut makalah yang diterbitkan di The Lancet Diabetes & Endocrinology membantu meningkatkan pertahanan tubuh terhadap penyakit menular, termasuk infeksi saluran pernapasan.
Pada dasarnya, jenis vitamin yang larut dalam lemak ini dapat membantu tubuh melawan kuman dan memulihkan dampak paparan patogen seperti bakteri atau virus.
Kekurangan vitamin D dikaitkan dengan gangguan daya tahan tubuh, yang membuat tubuh menjadi lebih mudah terserang infeksi yang menimbulkan gangguan seperti batuk maupun pilek.
7. Kelelahan
Merasa lelah sepanjang waktu merupakan salah satu tanda paling umum kekurangan vitamin D. Menurut analisis yang dipublikasikan dalam jurnal Nutrients, vitamin D terlibat dalam pengaturan tidur, termasuk produksi hormon pemicu tidur seperti melatonin. Kalau tidur terganggu, tubuh akan terasa lelah keesokan harinya.
Secara teori kekurangan vitamin D parah dalam jangka panjang dapat menyebabkan pelunakan otot yang disebut rakhitis pada anak atau osteomalasia pada orang dewasa.
Dokter Cutler menyampaikan bahwa meskipun terkait dengan banyak kondisi, kekurangan vitamin D yang tidak kentara tidak pernah terbukti secara langsung menyebabkan atau berkontribusi pada penyakit apapun.
Menurut dia, pengayaan makanan seperti susu dan sereal dengan vitamin D bisa membantu menghilangkan risiko masalah tulang akibat kekurangan vitamin D.
Kebutuhan vitamin D dapat dipenuhi antara lain dengan berjemur di bawah sinar matahari, mengonsumsi makanan yang mengandung vitamin D seperti susu, kuning telur, serta ikan salmon, trout, makerel, sarden, atau tuna.
Orang-orang yang berisiko kekurangan vitamin D disarankan menjalani pemeriksaan di fasilitas pelayanan kesehatan, yang selanjutnya bisa merekomendasikan kebutuhan suplemen untuk membantu menangani gejala.
- Penulis :
- Nur Nasya Dalila